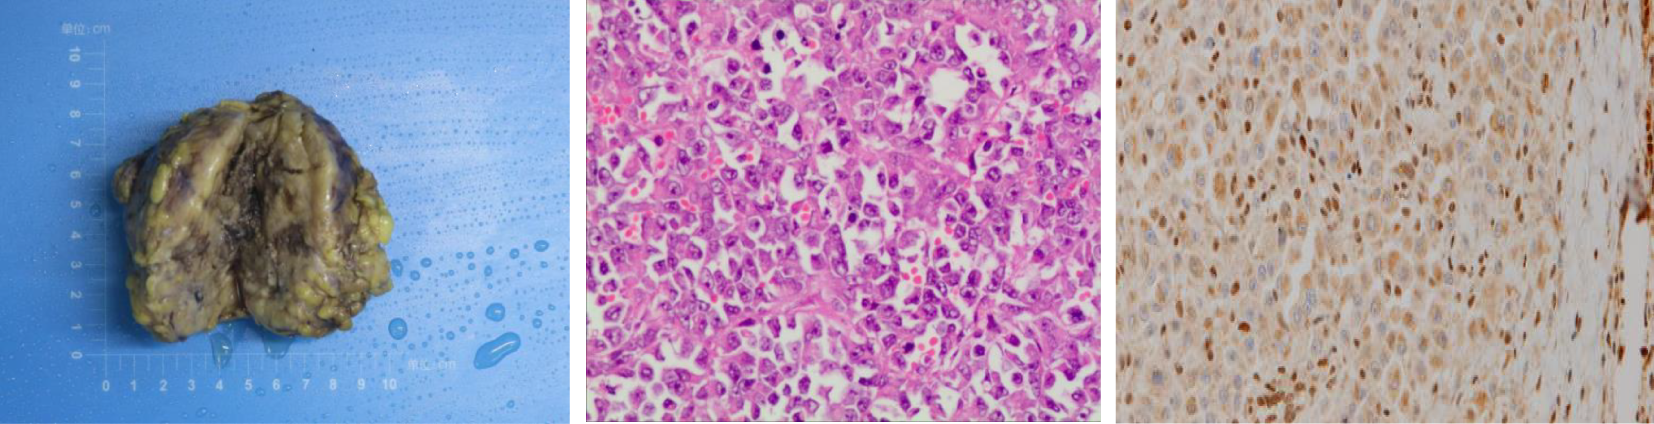
Three-panel image showing a specimen and histological slides. The first panel displays a yellow-brown lobulated mass on a blue background, resembling a pathological specimen. The second panel shows a microscopic view of densely packed purple-stained cells, indicating a tissue slide stained with hematoxylin and eosin. The third panel features another tissue slide with brown-stained cells, likely showing immunohistochemical staining results.

Abstract
Vulvar epithelioid sarcoma (ES) in pregnancy is an exceedingly rare condition, and only three reports are available to date. Optimal management is not well established. Herein, we report a 35-year-old woman who presented with a tender mass on the left labia majora at 33 weeks and 4 days of gestation. The patient underwent radical local resection of the lesion in the left vulva and left inguinal lymphadenectomy at 36 weeks and 4 days of gestation. Simultaneously, preterm cesarean section was performed because of mature fetus indicated by ultrasonography. Pathology of the lesion demonstrated a 7×5×5 cm-sized ES with the infiltration of surrounding adipose tissue, and no necrosis, hemorrhage, or venous invasion were identified. Six weeks after surgery, the patient underwent tumor resection due to recurrence. Then, adjuvant radiotherapy was performed with a dose of 40 Gy/10 cycles, followed by 15 Gy/3 cycles with a 10×10 cm field. The patient survived with neither recurrence nor complications at a 12-month follow-up. This case highlights management of a rare disease in pregnancy, with radical local resection of the lesion and lymphadenectomy combined with cesarean section.
Introduction
The combination of cancer and pregnancy is rare, as already demonstrated by the occurrence of 0.05% to 0.1% in all pregnancies (1). In particular, vulvar epithelioid sarcoma (ES) is an exceedingly rare condition and comprises approximately 1% of soft tissue sarcomas (2). Standard treatment of this rare tumor is radical local excision with unilateral or bilateral lymph node dissection or sentinel node procedure according to guidelines published in 2019 (3). However, recommendations of the previous guidelines were usually not very specific for vulvar ES during pregnancy. To the best of our knowledge, only three vulvar ES cases during pregnancy have been reported in English literature to date (4–6). Two cases involved women who either died after delivery or were lost to follow-up at 16 weeks of gestation. Successful management was achieved in a 36-year-old Japanese woman who underwent tumor resection at 23 weeks of gestation. Then, cesarean section, radical vulvectomy, and lymphadenectomy were performed at 29 weeks of gestation. This is the second successful management reported in a pregnant woman and the first to describe a successful regimen consisting of cesarean section and surgical resection simultaneously in late pregnancy, which is more challenging.
Case report
Initial discovery of the mass
A 35-year-old Chinese woman, gravida 4 para 3, had presented to another hospital with a tender nodule on the left labia majora at 33 weeks and 4 days of gestation in 2024. She had noticed a soybean-sized mass on the left side of her vulva 7 months earlier, but its dimensions had been stable until the last 6 weeks (at 27 weeks and 5 days of gestation), when it began to grow. No evidence of comorbidity was noted. No previous gynecologic problems and chronic diseases such as hypertension, diabetes, and obesity were reported. She had no personal or family history of cancer.
Initial medical check-up
She had visited our hospital with a presumed diagnosis of Bartholin’s gland cyst at 34 weeks and 2 days of gestation. Upon gynecological examination, there was an indurateds and tender vulvar mass measuring 6×7×5 cm arising in the left labia majora. Ultrasonographic examination revealed an irregular solid mass with heterogenous hypoechoic structure, sized 58×49×46 mm (Figure 1). The patient underwent needle biopsy for the lesion at 34 weeks and 4 days of gestation, and pathology showed a malignant epithelioid tumor. Five days after needle biopsy, magnetic resonance imaging showed a soft tissue neoplasm measuring 63×59×53 mm over the left labia majora with high signal on T1/T2-weighted imaging (WI). There was a restriction in the diffusion-weighted imaging (DWI) (Figure 1). In addition, a computerized tomographic scan of the pelvis, abdomen, and chest suggested no metastasis. At 36 weeks of gestation, Doppler ultrasonography revealed fetal biparietal diameter (BPD), femur length (FL), head circumference (HC), and abdominal circumference (AC) to be 9.0, 7.1, 32.7, and 32.4 cm, respectively. Placental maturity: Grade I; amniotic fluid index (AFI): 14.5 cm; umbilical artery blood flow: S/D = 2.12.
Figure 1

Left: Real-time ultrasonogram of the lesion. Right: Magnetic resonance imaging of the pelvic.
Surgical treatment
Based on the results from ultrasonography combined with fetal heart electronic monitoring and clinical evaluation (cervical ripening, pregnant women’s weight, and uterine height), experts in obstetrics and neonatology suggested that there was a high possibility of fetal maturity although amniocentesis was not conducted. Prophylactic corticosteroids for facilitation of fetal lung maturation were not administered due to their controversy from 34 to 36 + 6 weeks of gestation. According to guidelines from the American College of Obstetricians and Gynecologists (7), corticosteroids are recommended for women from 34 to 36 + 6 weeks of gestation who may have premature birth within 1 week. Subsequently, the obstetrics team performed preterm cesarean section, and the gynecology team performed radical local resection of the lesion on the left labia majora and left inguinal lymphadenectomy at 36 weeks and 4 days of gestation. Final pathology of the specimen demonstrated a 7-cm-sized ES with the infiltration of surrounding adipose tissue, and no necrosis, hemorrhage, or venous invasion were identified. Surgical resection margins were clear and free of tumor (distance of 2 cm from biopsy lesion). There were no lymphovascular emboli, perineurial invasion, or regional lymph node metastasis. Immunohistochemically, the tumor cells were positive for EMA, SMA, IMP3, and vimentin, while negative for S100, Desmin, Myogenin, MyoD1, and CD34. INI-1 expression was lost in tumor cells (Figure 2). Morphologically, it is necessary to distinguish ES from other epithelioid-looking tumors such as epithelioid peripheral nerve sheath tumor, epithelioid leiomyosarcoma, epithelioid angiosarcoma, rhabdomyosarcoma, malignant melanoma, and poorly differentiated squamous cell carcinoma. The diagnosis can only be confirmed with immunohistochemical staining, and the case was sent to a pathologist, for a second opinion, who agreed with the diagnosis of ES. The final diagnosis was proximal-type vulvar ES. The female newborn weighed 2,900 g, and the Apgar score was 9/10 (at 1 min/5 min). The newborn was not incubated and subsequently discharged uneventfully.
Figure 2
Left: Gross appearance of a local resection specimen showing a tumor with a grey-white cut surface. Middle: Microscopic appearance. Tumour is composed of epithelioid cells. H and E, x 400. Right: Loss of INI-1 expression in nuclear of tumor cells.
After surgery
Postoperatively, the patient experienced lymphatic leakage and surgical site infection of inguinal lesions, and required 1 month for the healing of the wound. Six weeks after surgery, she presented with a recurrent painless nodule on the left labia majora, and ultrasonographic imaging revealed a subcutaneous solid mass measuring 15×13×10 mm and a solid mass of subcutaneous fat layer near the midline of the lower left abdomen. She underwent excision of the lesion. Pathology was suggestive of tumor recurrence with the infiltration of surrounding adipose tissue, no venous or neural invasion, and free-tumor surgical margins. Then, she was transferred to a tumor hospital where she received adjuvant radiotherapy with a dose of 40 Gy/10 cycles, followed by 15 Gy/3 cycles with a 10×10 cm field. The patient survived with neither recurrence nor complications at a 12-month follow-up.
Discussion
Vulvar ES is a malignant tumor of mesenchymal origin with a recurrence rate of 38%–69% (8). This tumor manifests as having a predominantly large-cell, epithelioid cytomorphology, with marked cytologic atypia and frequent occurrence of rhabdoid features microscopically (8). Vulvar ES generally occurs in women of reproductive age, and its risk factors remain unknown due to its rarity. Immunohistochemical staining is useful for microscopic diagnosis of vulvar ES, in which a lack of staining for INI-1 protein is a characteristic finding (8). In the present case, this feature supported the pathological diagnosis of vulvar ES.
The general consensus of vulvar ES in pregnancy is immediate surgical resection (3). Currently, complete surgical excision is the best treatment option and is possible in all trimesters, but it is preferably carried out in the second or third trimester to decrease the risk of miscarriage (3). Lymphadenectomy should also be considered in the presence of lymph node metastasis (8). However, the mode of delivery and optimal opportunity for cesarean section remain experimental. In the present case, the diagnosis of vulvar ES was made in the third trimester, and ultrasonography revealed a mature fetus; thus, cesarean section in combination with tumor removal was administered. We also performed left inguinal lymphadenectomy as a staging and cytoreductive procedure, although the patient had no lymph node metastasis at the time of presentation. As she later had recurrence on the left labia majora and no groin node metastasis was observed, it may be beneficial to perform inguinal lymph node dissection in the case of an aggressive form of vulvar cancer.
Whether adjuvant therapies such as radiotherapy and chemotherapy bring favorable outcomes is unclear. Radiotherapy is commonly offered in case of positive margins or recurrent settings (8). In addition, anthracycline-based and gemcitabine-based regimens have shown some benefits in cases of unresectable or metastatic ES (9). In this case, radiotherapy is offered due to recurrence. As patients did not encounter relapse at a 12-month follow-up, it may be useful to start with radiotherapy in the case of recurrence.
It is noteworthy that vulvar ES is frequently misdiagnosed as a benign lesion such as Bartholin’s cyst, lipoma, or genital wart due to its rarity and usual presentation as a solitary painless lump (10). Thus, accurate early-stage diagnosis and management are important. Physicians should be alert when patients present with a palpable nodule in the vulva, especially in reproductive-age women, for a potentially better prognosis. Moreover, in this case, the patient and her family members were provided with the knowledge on vulvar ES with a step-by-step approach so that they were able to adjust and find strength. Through this process, the patient could accept disease-related experiences and develop a rational perspective.
Conclusion
Aggressive approaches such as radical local resection of the lesion, cesarean section, and lymphadenectomy can improve maternal–neonatal outcomes in the case of vulvar ES during pregnancy. Moreover, radiotherapy in the case of recurrence is important.
Statements
Data availability statement
The original contributions presented in the study are included in the article/supplementary material. Further inquiries can be directed to the corresponding authors.
Ethics statement
The studies involving humans were approved by the Research Ethics Board of the Third Affiliated Hospital of Southern Medical University. The studies were conducted in accordance with the local legislation and institutional requirements. The participants provided their written informed consent to participate in this study. Written informed consent was obtained from the individual(s) for the publication of any potentially identifiable images or data included in this article.
Author contributions
XG: Conceptualization, Data curation, Formal analysis, Methodology, Resources, Writing – original draft. RL: Data curation, Formal analysis, Resources, Writing – review & editing. YL: Data curation, Formal analysis, Investigation, Writing – review & editing. RX: Conceptualization, Investigation, Supervision, Validation, Writing – review & editing.
Funding
The author(s) declare that no financial support was received for the research and/or publication of this article.
Acknowledgments
We are grateful to the pregnant woman and her family who took time to participate in the study.
Conflict of interest
The authors declare that the research was conducted in the absence of any commercial or financial relationships that could be construed as a potential conflict of interest.
Generative AI statement
The author(s) declare that no Generative AI was used in the creation of this manuscript.
Publisher’s note
All claims expressed in this article are solely those of the authors and do not necessarily represent those of their affiliated organizations, or those of the publisher, the editors and the reviewers. Any product that may be evaluated in this article, or claim that may be made by its manufacturer, is not guaranteed or endorsed by the publisher.
References
1
Javitt MC . Cancer in pregnancy: overview and epidemiology. Abdom Radiol (NY). (2023) 48:1559–63. doi: 10.1007/s00261-022-03633-y , PMID:
2
Korenaga TK Tewari KS . Gynecologic cancer in pregnancy. Gynecol Oncol. (2020) 157:799–809. doi: 10.1016/j.ygyno.2020.03.015 , PMID:
3
Amant F Berveiller P Boere IA Cardonick E Fruscio R Fumagalli M et al . Gynecologic cancers in pregnancy: guidelines based on a third international consensus meeting. Ann Oncol. (2019) 30:1601–12. doi: 10.1093/annonc/mdz228 , PMID:
4
Orita Y Kamio M Tokudome A Kitazono I Ichihara F Kobayashi H . Successful management of vulvar proximal-type epithelioid sarcoma in pregnancy. Gynecol Oncol Rep. (2022) 39:100933. doi: 10.1016/j.gore.2022.100933 , PMID:
5
Moore RG Steinhoff MM Granai CO DeMars LR . Vulvar epithelioid sarcoma in pregnancy. Gynecol Oncol. (2002) 85:218–22. doi: 10.1006/gyno.2002.6610 , PMID:
6
Rai H Odunsi K Kesterson J Morrison C Chan A Mhawec-Fauceglia P . Epithelioid sarcoma of the vulva in a 17-year-old pregnant woman. Appl Immunohistochem Mol Morphol. (2009) 17:270–3. doi: 10.1097/PAI.0b013e31818eca8b , PMID:
7
Beihua K Ding M Tao D . Gynecology & Obstetrics. Beijing, China: Peoplle’s Health Publishing House (2024).
8
Dash B Rekhi B Shylasree TS Maheshwari A Bajpai J . Proximal -type epithelioid sarcoma of vulva - Case series of a rare tumor. Gynecol Oncol Rep. (2022) 39:100921. doi: 10.1016/j.gore.2022.100921 , PMID:
9
Frezza AM Jones RL Lo Vullo S Asano N Lucibello F Ben-Ami E et al . Anthracycline, Gemcitabine, and Pazopanib in epithelioid sarcoma: A multi-institutional case series. JAMA Oncol. (2018) 4:e180219. doi: 10.1001/jamaoncol.2018.0219 , PMID:
10
Chung H Jang TK Kwon SY Ha J Shin SJ . A proximal type epithelioid sarcoma of the vulva with multiple distant metastases: Acase report and review of the literature. Gynecol Oncol Rep. (2021) 37:100835. doi: 10.1016/j.gore.2021.100835 , PMID:
Summary
Keywords
pregnancy, epithelioid sarcoma, vulva, case report, cesarean
Citation
Guo X, Li R, Liu Y and Xiong R (2025) Successful management for vulvar epithelioid sarcoma during pregnancy: a rare case report. Front. Oncol. 15:1570151. doi: 10.3389/fonc.2025.1570151
Received
03 February 2025
Accepted
25 June 2025
Published
18 July 2025
Volume
15 - 2025
Edited by
Cristina Secosan, Victor Babes University of Medicine and Pharmacy, Romania
Reviewed by
Manuel Jr. Vidal, San Beda University, Philippines
Victor Manuel Vargas-Hernandez, Academia Mexicana de Cirugia and Academia Nacional de Medicina de Mexico, Mexico
Updates
Copyright
© 2025 Guo, Li, Liu and Xiong.
This is an open-access article distributed under the terms of the Creative Commons Attribution License (CC BY). The use, distribution or reproduction in other forums is permitted, provided the original author(s) and the copyright owner(s) are credited and that the original publication in this journal is cited, in accordance with accepted academic practice. No use, distribution or reproduction is permitted which does not comply with these terms.
*Correspondence: Yan Liu, 19714343@qq.com; Ribo Xiong, xiongribo@outlook.com
Disclaimer
All claims expressed in this article are solely those of the authors and do not necessarily represent those of their affiliated organizations, or those of the publisher, the editors and the reviewers. Any product that may be evaluated in this article or claim that may be made by its manufacturer is not guaranteed or endorsed by the publisher.